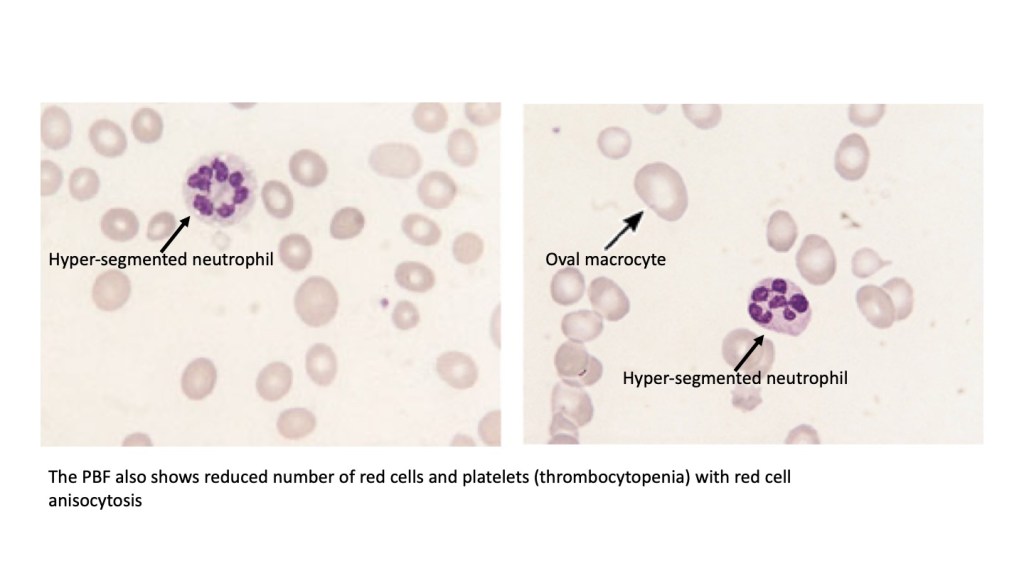

Learning outcomes
- List the common causes associated with macrocytic anaemia
- Describe the bone marrow and peripheral blood film features of megaloblastic anaemia
Causes of macrocytosis
Red cell macrocytosis is defined as the appearance of larger than normal red blood cells in the circulation, characterised by an increase in mean cell volume (MCV), above 100 fl.
Increase in red cell size can usually be attributed to two groups;
The non megaloblastic macrocytic anaemias include;
- Abnormalities of the red cell membrane as a result of changes in the lipid composition of the membrane. such as in liver dysfunction, alcoholism and hypothyroidism
- Aplastic anaemia
- Myelodysplastic syndrome
and megalobastic anaemias that are principally due to;
- Vitamin B12 (cobalamin) deficiency
- Folate deficiency
- Drugs that interfere during with pyrimidine synthesis
Also to note, MCV may sometimes appear raised in the absence of large red cells as a consequence of reticulocytosis (which are naturally bigger than mature erythrocytes) or when red cells clump together in cold haemagglutinin disease (CHAD).
Megaloblastic anaemia
Bone marrow features
Megaloblastic maturation is a term applied to a specific type of maturational disturbance involving haematopoietic cells. The condition occurs due to impaired DNA synthesis which interferes with cell division. As a consequence, nuclear maturation which is dependant on precise DNA divisions is interrupted, resulting in a mismatch or asynchrony between development of the nucleus and the cytoplasm at each cell division.
In the marrow, megaloblastosis is characterised by the presence of large erythroid precursors called megaloblasts (see figure below). Megaloblastic maturation can also effect other cells, but it is most prominent among erythroid cells as these are most actively dividing cells of the body. Large granulocytic precursors (giant metamyelocytes) and megakaryocytes can also be seen in the bone marrow.
In severe cases, megaloblastic changes can also be seen in intestinal mucosal cells and dermal cells which also have high turnover.

Full blood count (FBC) and peripheral blood film (PBF) examination
The FBC in patients with megaloblastic anaemia will show:
- Low haemoglobin
- High MCV (usually above 110 fl)
- Low red blood count (RBC)
- High red distribution width (RDW)
- Low or normal reticulocyte count (unless patient has been started on treatment)
- Low platelets and neutrophils (patients with megaloblastic anaemia often have pancytopenia as the maturational disturbances effect all haematopoietic cell lines)
Characteristic features that are seen on peripheral blood film examination include
- Macrocytosis and anisocytosis
- Large oval macrocytes (this is a useful feature to distinguish non-megaloblastic from megaloblastic macrocytosis, as non-megaloblastic causes usually have round microcytes instead of oval macrocytes)
- Hypersegmented neutrophils